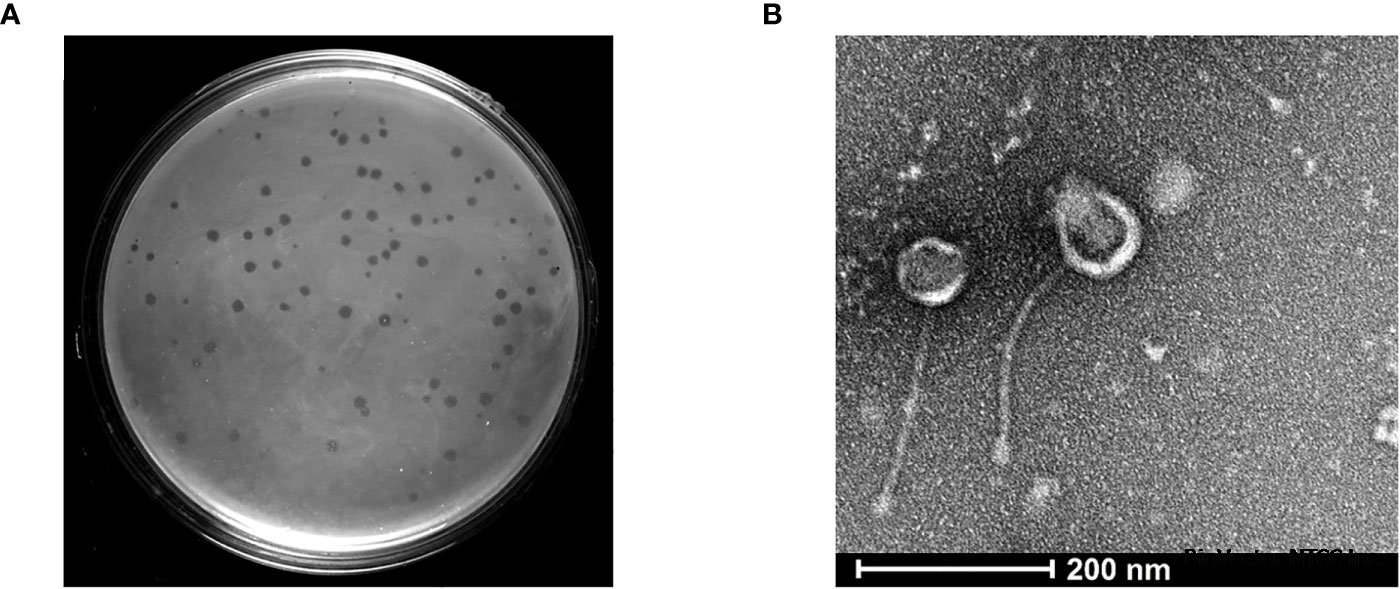
Frontiers | Isolation and characterization of a novel mycobacteriophage  Kashi-VT1 infecting Mycobacterium species

耻垢分枝杆菌噬菌体BioVector® Mycobacteriophage
- 价 格:¥99850
- 货 号:BioVector® Mycobacteriophage
- 产 地:北京
- BioVector NTCC典型培养物保藏中心
- 联系人:Dr.Xu, Biovector NTCC Inc.
电话:400-800-2947 工作微信:1843439339 (QQ同号)
邮件:Biovector@163.com
手机:18901268599
地址:北京
- 已注册
BioVector®耻垢分枝杆菌噬菌体(Mycobacteriophage)是能够特异性感染分枝杆菌属细菌(主要以耻垢分枝杆菌为模型宿主)的一类病毒。
宿主范围:主要宿主为耻垢分枝杆菌(M. smegmatis),部分菌株(如D29、Celfi)可跨属感染结核分枝杆菌(M. tuberculosis)。
形态学特征:多数属于长尾病毒科(Siphoviridae),具有二十面体头部和长而不收缩的尾部。
代表性株系:D29、TM4、L5、Henu3、vB_MsmS_Celfi。
潜伏期与释放量:感染周期通常包括20-60分钟的潜伏期,具体取决于株系,裂解产毒量(Burst size)较大。
耐热性:在60°C以下表现稳定,部分菌株可耐受高达72°C的高温。
pH稳定性:在pH 4.0至pH 10.0范围内通常能保持感染活性。
基因组大小:通常在40 kb至160 kb之间(双链DNA),基因排布呈现高度的嵌合性(Mosaicism)。
基因工程工具:利用其整合酶(如L5或Bxb1整合酶)构建分枝杆菌的穿梭质粒或基因定点整合系统。
检测诊断:开发为荧光噬菌体或利用其特异性结合蛋白(如Gp6、Gp10)快速识别环境中或临床样本中的分枝杆菌。
噬菌体疗法:由于耻垢分枝杆菌生长快、无致病性,常被用作筛选广谱抗分枝杆菌噬菌体的“诱饵”菌,用于治疗耐药性结核或非结核分枝杆菌(NTM)感染。
储存温度:短期使用建议4°C避光保存;长期保存需在包含15-20%甘油的SM缓冲液中置于-80°C。
增殖条件:常用耻垢分枝杆菌mc²155菌株作为扩增宿主,使用7H9液体培养基或7H10琼脂,37°C孵育。
安全性:大多数对耻垢分枝杆菌特异的噬菌体对人类无害,但在涉及结核分枝杆菌交叉实验时,必须在BSL-3实验室进行。

BioVector® Mycobacteriophage
Target Host: Primarily Mycobacterium smegmatis (e.g., strain mc²155). Some broad-spectrum variants also infect M. tuberculosis and M. abscessus.
Taxonomy: Most belong to the family Siphoviridae (long, non-contractile tails) or Myoviridae (contractile tails).
Life Cycle: Can be Lytic (immediate host lysis) or Temperate (integrate into the host genome as a prophage).
Common Clusters: Organized into clusters (A through Z) based on genomic similarity (e.g., D29 is Cluster AD, L5 is Cluster A1).
Thermal Stability: Generally stable between 4°C and 55°C. Significant titer loss typically occurs above 65°C.
pH Tolerance: Optimal stability at pH 7.0–8.0. Most strains remain viable within the pH 4.0 to 10.0 range.
Storage Buffers: Best maintained in Phosphate Buffered Saline (PBS) or SM Buffer (Tris-HCl, NaCl,
您正在向 biovector.net 发送关于产品 耻垢分枝杆菌噬菌体BioVector® Mycobacteriophage 的询问
- 公告/新闻




